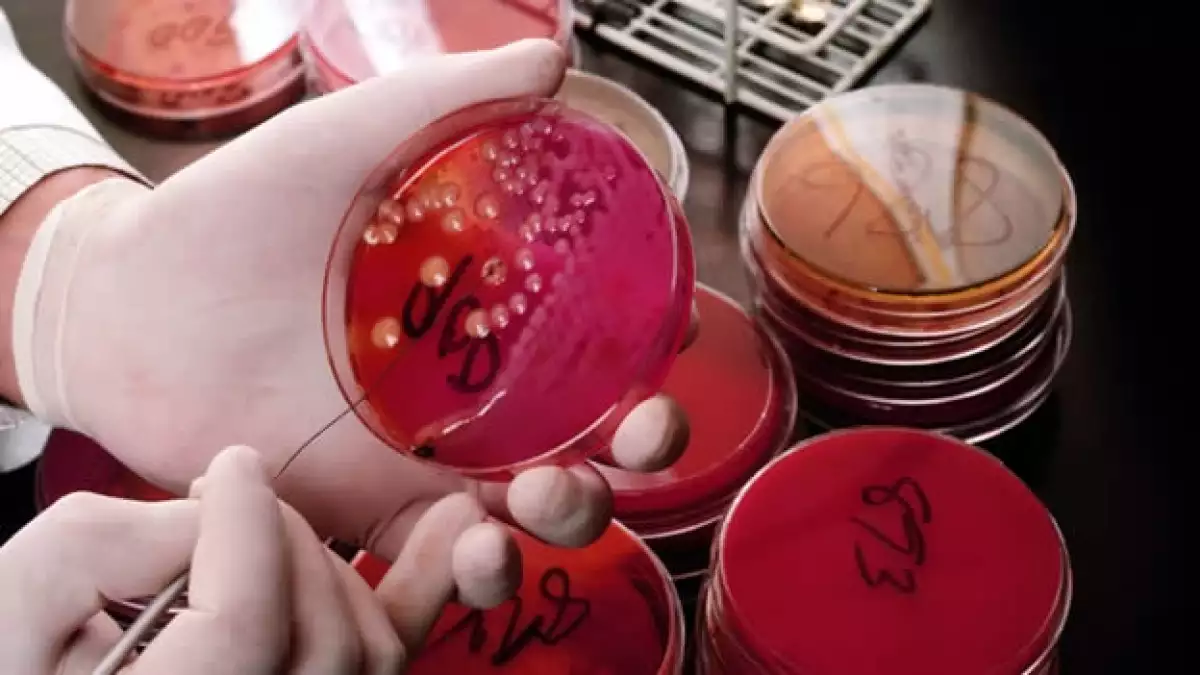

La proteína HLA-B podría ser la clave en la inmunidad al VIH/Sida
Aún no hay vacuna para el VIH, pero los investigadores han descubierto nuevas pistas para saber por qué una minoría de personas infectadas puede ser portadora del virus sin mostrar síntomas.
Sólo una de cada 300 personas infectadas tiene un sistema inmunológico que naturalmente puede inhibir la duplicación del virus y, por lo tanto, pueden portar bajos niveles del virus.
Algunas variaciones genéticas específicas pueden ser responsables de esta reacción poco común al VIH, según el estudio publicado en la revista Science.
"Esto indica que el sistema inmunológico definitivamente juega un papel importante en la gente que se infecta y en quienes no progresa la enfermedad", dijo la coautora de la investigación Florencia Pereyra, quien estableció el Estudio Internacional de Controladores del VIH, que ha suscrito a más de 1,500 personas con VIH que mostraron una capacidad natural para controlar el virus . "Realmente nos ayuda a aplicar gran parte de la investigación".
En este estudio, un equipo internacional de investigadores analizó el genoma de casi 1,000 controladores, gente que puede controlar el virus en su sistema de forma natural, y a 2,600 individuos con infecciones progresivas de VIH.
Descubrieron que hay pequeñas variantes en una proteína llamada HLA-B, que puede ser la responsable de la capacidad de controlar bien el virus. En las personas con diferencias particulares en cinco aminoácidos componentes de la proteína, la respuesta inmunológica contra el VIH es más fuerte.
Pereyra lo explica de la siguiente manera: Imagina que hay un obrero que toma un pedazo del virus, y grita identificándolo. Esa es la entrada para que el sistema inmunológico pueda llegar al combate.
En la gente que tiene diferencias específicas, sus linfocitos T, las células de la sangre que nos protegen contra las infecciones, parecen detener el virus de su camino destructivo, visto en la mayoría de las personas VIH positivas. Algunas personas han vivido de forma asintomática durante más de 30 años y no toman ningún medicamento para combatir el VIH.
En algunos controladores de élite, el virus no puede ser detectado en pruebas tradicionales de VIH , pero la firma del virus aún está presente.
El descubrimiento sobre la genética sugiere que el sistema inmunológico puede ser manipulado para hacer que los individuos infectados puedan controlar mejor el VIH, pero los investigadores aún están lejos de poder aplicar esto a alguna vacuna o incluso a un tratamiento , dijo Pereyra.
"Éste es sólo un paso adelante y definitivamente vamos en la dirección correcta", dijo Pereyra.